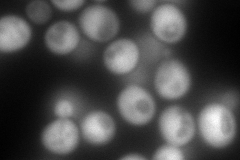
YGR037C
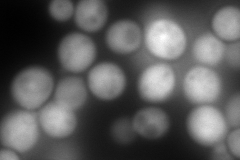
YGR037C
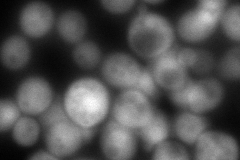
YGR037C
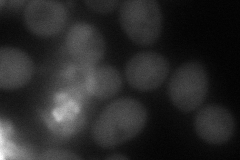
YGR037C
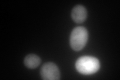
YGR037C
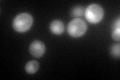
YGR037C

View description
Acyl-CoA-binding protein, transports newly synthesized acyl-CoA esters from fatty acid synthetase (Fas1p-Fas2p) to acyl-CoA-consuming processes
Localization:
Intensity:
Fold change:
Significance:
-
C’ GFP library in SD

cytosol184.47 -
N' NOP1pr-GFP in SD
cytosol350.5 -
N' TEF2pr-mCherry in SD
cytosol723.011 -
N' NATIVEpr-GFP in SD
cytosol158.882 -
N' TEF2pr-VC and Cyto-VN in SD
cytosol80.2921 -
C’ GFP library in SD+DTT
cytosol344.961.87Yes -
C’ GFP library in SD+H2O2

cytosol218.621.18No -
C’ GFP library in Starvation Media
cytosol276.11.49Yes -
C’ GFP library on the background of Pup2-DaMP

cytosol -
C’ GFP library on the background of CCT mutant

cytosol150.4480.815554No
